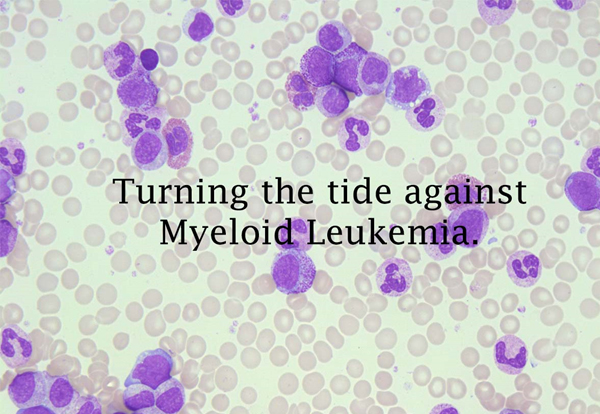

Blogs

By Admin, 4 Nov 2022
What is factor V Leiden?
Factor V Leiden is a condition that makes blood more likely to form clots in the legs, lungs, and other parts of the body....
Read More
By Admin, 4 Nov 2022
What is Hemophilia?
Hemophilia is a condition that keeps blood from clotting normally.
Read More
By Admin, 2 December 2022
Here we are today to discuss a common hematological or blood problem
Deep vein thrombosis is the medical term for a blood clot in the deep veins of the leg.Deep vein thrombosis, or "DVT," can be dangerous.
Read More
By Admin, 15 December 2022
What is Bone Marrow ??
The bone marrow is one of the most widely distributed organs in the human body. It is the principal site of blood formation beginning at the time of birth, at which time all bone cavities are filled with hematopoietic tissue.
Read More
By Admin, 23 March 2022
Hairy cells in peripheral smears
Hairy cell leukemia (HCL) is an indolent neoplasm of mature B lymphoid cells representing approximately 2 percent of all leukemias and <1 percent of lymphoid neoplasms.
Read More
By Admin, 23 March 2022
What is Febrile Neutropenia?
It is a medical condition that occurs when a person with a low white blood cell count (neutropenia) develops a fever, typically with a body temperature of 100.4°F (38°C) or higher.
Read More
By Admin, 23 March 2022
What is Thalassemia?
Thalassemia is a condition that affects red blood cells.
Red blood cells are made inside your bones, in a part called the bone marrow.

By Admin, 23 March 2022
What is ANEMIA?
Anemia is the term for when a person does not have enough of something called "hemoglobin" in their blood.
Read More
By Admin, 23 March 2022
What are the tests for Thalassemia ??
History and physical examination — The history focuses on the following:
Family history (FH)
FH of thalassemia can help determine type and severity of thalassemia.

By Admin, 23 March 2022
What is sickle cell disease?
Sickle cell disease (SCD) is an inherited group of disorders characterized by the presence of hemoglobin S (Hb S), either from homozygosity for the sickle mutation (Hb SS) or compound heterozygosity...
Read More
By Admin, 23 March 2022
What are the tests in sickle cell anemia?
Various tests are used to diagnose and monitor sickle cell anemia and its complications. Here are some common tests associated with this condition:
Read More
By Admin, 23 March 2022
Treatment of sickle cell anemia?
Vaso-occlusive phenomena and hemolysis are the clinical hallmarks of sickle cell disease. Vaso-occlusion results in recurrent painful episodes (previously called sickle cell crisis) and a variety of serious organ system complications that can lead to life-long disabilities and even death.
Read More
By Admin, 23 March 2022
What causes iron deficiency anemia ?
Inadequate Dietary Iron Intake: A diet consistently low in iron-rich foods, such as red meat, poultry, fish, beans, lentils, and leafy greens, can result in be insufficient iron intake.
Read More
By Admin, 23 March 2022
What are the tests in iron deficiency anemia?
Complete Blood Count (CBC): This test measures the number of red blood cells, hemoglobin levels, hematocrit, and other blood components. In iron deficiency anemia, red blood cell counts and hemoglobin levels are typically lower than normal.
Read More
By Admin, 23 March 2022
What are the treatment modalities in iron deficiency anemia?
Iron Supplements: The most common treatment for iron deficiency anemia is oral iron supplements. These are available by prescription from you HEMATOLOGIST. They should be taken as directed by a HEMATOLOGIST.
Read More
By Admin, 23 March 2022
What is Megaloblastic Anemia?
Megaloblastic anemia is a type of anemia characterized by the presence of abnormally large red blood cells (megaloblasts) in the bone marrow.
Read More
By Admin, 23 March 2022
What is Treatment of Megaloblastic Anemia?
Megaloblastic anemia is a type of anemia characterized by the presence of abnormally large red blood cells (megaloblasts) in the bone marrow.
Read More
By Admin, 23 March 2022
What is Aplastic Anemia?
Megaloblastic anemia is a type of anemia characterized by the presence of abnormally large red blood cells (megaloblasts) in the bone marrow.
Read More
By Admin, 23 March 2022
What is Polycythemia Vera?
Polycythemia vera (PV) is a rare, chronic blood disorder characterized by the overproduction of red blood cells in the bone marrow.
Read More
By Admin, 23 March 2022
What is Hemophilia?
Hemophilia is a rare genetic disorder that affects a person's ability to form blood clots.
Read More
By Admin, 23 March 2022
What is Hemophilia?
Hemophilia is a rare genetic disorder that affects a person's ability to form blood clots.
Read More
By Admin, 23 March 2022
What Happens In Hemophilia?
Prolonged Bleeding: Individuals with hemophilia tend to bleed for a longer time than others after an injury, surgery, or even minor cuts and bruises. This prolonged bleeding is a hallmark symptom of the disorder.
Read More
By Admin, 23 March 2022
What Happens In Hemophilia?
Prolonged Bleeding: Individuals with hemophilia tend to bleed for a longer time than others after an injury, surgery, or even minor cuts and bruises. This prolonged bleeding is a hallmark symptom of the disorder.
Read More
By Admin, 23 March 2022
What Happens In Hemophilia?
Prolonged Bleeding: Individuals with hemophilia tend to bleed for a longer time than others after an injury, surgery, or even minor cuts and bruises. This prolonged bleeding is a hallmark symptom of the disorder.
Read More
By Admin, 23 March 2022
What is Hemolytic Anemia ?
Hemolytic anemia is a condition where your body destroys red blood cells faster than it can produce them. This can lead to a shortage of red blood cells, which are responsible for carrying oxygen to your body's tissues.
Read More
By Admin, 23 March 2022
What is Hemolytic Anemia ?
HUnderstanding Thrombocytopenia: Causes, Symptoms, and Treatment.
Read More
By Admin, 4 Nov 2022
Awareness Alert: Chronic Myeloid Leukemia
Join me in spreading awareness about Chronic Myeloid Leukemia (CML), a rare but manageable blood cancer. 🌟 CML might be a challenge, but with the right treatment and support, we can overcome it.
Read More
By Admin, 4 Nov 2022
What Is Thrombocytosis ?
Thrombocytosis – Thrombocytosis is defined as a platelet count >450,000/microL (>450 x 109/L) in adults and children
Read More
By Admin, 4 Nov 2022
What Is A Bone Marrow Transplant ?
A bone marrow transplant is a procedure that replaces abnormal or missing cells...
Read More
By Admin, 4 Nov 2022
What is follicular lymphoma?
Follicular lymphoma is a type of lymphoma. Lymphoma is cancer of the lymphatic system.
Read More
By Admin, 4 Nov 2022
What is diffuse large B cell lymphoma?
Diffuse large B cell lymphoma, or “DLBCL,” is a type of lymphoma. Lymphoma is a cancer of lymphocytes, which are infection-fighting cells of the body’s lymphatic system.
Read More
By Admin, 4 Nov 2022
What is Burkitt’s Lymphoma?
Burkitt’s lymphoma, a rare and aggressive form of non-Hodgkin lymphoma, poses unique challenges for patients and healthcare professionals alike.
Read More
By Admin, 20 Dec 2023
What are myelodysplastic syndromes?
Myelodysplastic syndromes (“MDS”) are a group of conditions that involve blood. Blood is made up of different types of cells. These cells are made in the center of bones, in a part called the bone marrow...
Read More
By Admin, 20 Dec 2023
What is multiple myeloma?
Multiple myeloma, or “MM,” is a cancer of the “plasma cells.” Plasma cells are a type of white blood cell. White blood cells fight infections in the body. They are made in the center of the bones, in a part called the bone marrow.
Read More
By Admin, 20 Dec 2023
What is Hodgkin lymphoma?
Hodgkin lymphoma (which used to be called "Hodgkin's disease") is a type of lymphoma. Lymphoma is a cancer of white blood cells called "lymphocytes."
Read More
By Admin, 3 Jan 2024
What is Hodgkin lymphoma?
Hodgkin lymphoma (which used to be called "Hodgkin's disease") is a type of lymphoma. Lymphoma is a cancer of white blood cells called "lymphocytes."
Read More
By Admin, 3 Jan 2024
Bone Marrow Transplants
Bone marrow transplants (BMT), also known as hematopoietic stem cell transplants, are a medical procedure that has revolutionized the treatment of various life-threatening diseases,"
Read More

